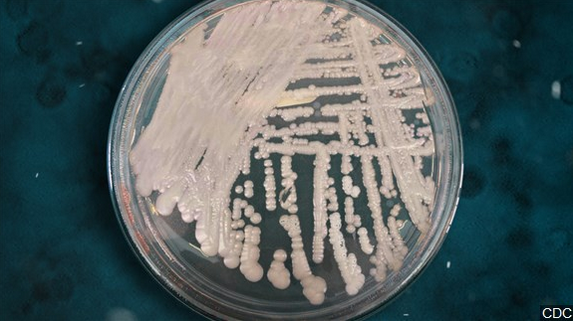

Service Center Provides One Stop Shop For Veterans
DULUTH, Minn. – “For the Vietnam veterans and those that lived through the draft, they answered the call,” Virginia Veteran Service Officer, Tyler Behnke says. There are just under 18,000 veterans in St. Louis County alone. Some of them may have variety of questions, and the service center has answers. “We’re just kind of like a clearing house or google…